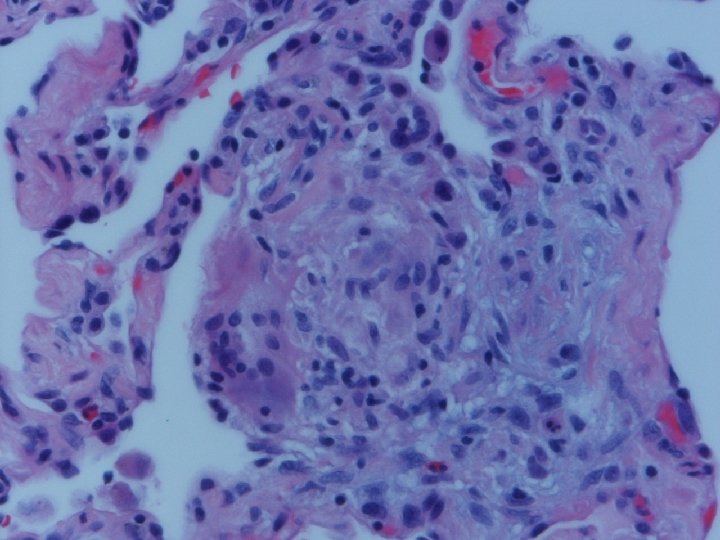

Hypersensitivity Pneumonias Wyatt E Rousseau MD May 10

- Slides: 36
Hypersensitivity Pneumonias Wyatt E. Rousseau, MD May 10, 2007
Hypersensitivity Pneumonitis Extrinsic Allergic Alveolitis A syndrome characterized by diffuse inflammation of lung parenchyma and airways in response to inhalation of antigens to which the patient has been previously sensitized
HP – Incidence and Mortality • General population based cohort study from a UK primary care database: 271 cases from 1991 -2003, approx. 0. 9 per 100, 000 person years. Mean age at diagnosis 57; male=female • Increased risk of dying (hazard ratio 2. 98) • Less likely to smoke (OR 0. 56) Solaymani-Dodaran M, West J, Smith C, Hubbard R. Extrinsic allergic alveolitis: incidence and mortality in the general population. QJM 2007; 100: 233 -237.
Case Report BH, 50 y. o. WF NS, described three episodes in three weeks of SOB, chest tightness, and hemoptysis. Initial episode lasted 2 hours, asso. with fever and chills, T. to 101 F. , and tsp. of bloody phlegm. PMH: hysterx 1984, on Premarin, Lexapro, Neurontin, trazadone, calcium, Fosamax. Parents both smoked, F d. lung CA, M d. emphysema and bronchiectasis, D with asthma. Pt. had severe complications of arthroscopy-6 surgeries, 3 ½ years of immobilization until TKR in 12/02, with
lymphedema, but had become quite physically fit with resting pulse usually 47. On PE, macular, papular rash over abdomen, chest, and neck. No nodes, clear chest, and left leg was not more swollen than right. She had chest CT 2/10/04 considered normal, and Lung scan 2/12/04 suggesting airways disease with inhomogeneous perfusion and prolonged washout. I recommended some lab work including Ddimer, CRP, and a venous doppler. She declined; so I asked her to take a sputum cup to bring in if she coughed and I planned a
CTA if another episode. She called the next day after a worse episode of tightness, SOB, and hemoptysis. CTA 2/17/04 “tree in bud bilateral and diffuse” suggesting infection or inflammation. Bronchoscopy 2/18/07 appeared normal, with biopsies revealing “mild chronic inflammation. ” March 4 received report of outpatient sputum growing an AFB, and I assumed MAC, and discussed Abx therapy. She then decided on VATS OLBx. (Bronch and OLBx cultures were both negative ultimately. )
Lung biopsy revealed chronic bronchiolitis/ hypersensitivity pneumonitis (extrinsic allergic alveolitis) with opinion from Mayo Clinic path arriving on 3/30/04. “Hot tub lung due to MAC”. I recommended Prednisone 20 mg. daily, but she had major psychiatric complications for which Seroquel was added and prednisone reduced. X-ray, spirometry, and symptoms resolved. Prednisone tapered and stopped in late May. Recurrence of symptoms and rash in August/September.
HP -CT Findings • • • Ground glass opacities Poorly defined centrilobular nodules Mosaic attenuation on inspiration Air trapping on expiration Reticulation (fibrosis) when chronic Silva CI, Churg A, Muller NL. Hypersensitivity pneumonitis: spectrum of highresolution CT and pathologic findings. Am J Roentgenol 2007; 188: 334 -44.
Classification of HP • Acute HP • Subacute or Intermittent HP • Chronic progressive HP
Acute HP • Clinical-Abrupt • Lab-ESR, IGG, RA, CRP, LDH, BAL lymphocytosis, restrictive physiology • CXR-micronodular interstitial, but freq. normal-HRCT needed, but not absolute • Histopathology-poorly formed, noncaseating interstitial granulomas, monos, giant cells
Subacute or Intermittent HP • Clinical-gradual cough, dyspnea, fatigue, anorexia, wt. loss, malaise; tachypnea and rales • Lab-BAL lymphocytosis, hypoxemia. Restrictive or mixed spiro, decreased DLCO • CXR-nml, micronodular, reticular. HRCT micronodules, ground glass, emphysema, fibrosis • Histopathology- noncaseating granulomas, bronchiolitis with or w/o organizing pneumonia
Chronic Progressive HP • Clinical-insidious cough, dyspnea, fatigue, weight loss, clubbing • Lab-not very helpful-BAL lymphocytosis but not crisp; restrictive, but usually mixed. DL always reduced, and exertional hypoxemia • CXR-may be normal, but usually progressive fibrosis; emphysema often • Histopathology-granulomatous pneumonia, BO with or w/o OP, fibrosis
HP Diagnosis • Known exposure to antigen-History, environmental investigation, Ig. G antibodies • Compatible clinical, radiographic, and physiology • BAL lymphocytosis • Positive inhalation challenge • Histopathology
Clinical Prediction • Exposure to known antigen • Positive precipitating antibodies to that antigen • Recurrent symptoms • Inspiratory crackles • Sx occurring 4 -8 hours after exposure • Weight loss Lacasse Y, for the HP Study Group. Clinical Diagnosis of Hypersensitivity Pneumonitis. Am J Respir Crit Care Med 2003; 168: 952 -958.
Helpful Clues to Recognize HP • • Hx recurring pneumonias, esp. if some regularity Sx after moving to new house or job Pets, esp. birds, with patient or family Hx water damage to home or office Use of hot tub, sauna, or pool Others with similar sx or have left work for illness Pt feels better when away from home or office
HP Associated with Farming • • • Moldy hay, grain, silage-Farmer’s lung Mold on pressed sugar cane-Bagassosis Tobacco plants Mushroom workers Potato riddlers Cheese washers
HP Associated with Ventilation and Water-Related Contamination • • • Humidifier fever Unventilated shower Hot tub lung Sauna taker’s lung Lifeguard lung
HP Associated with Birds/Poultry • • • Bird fancier’s lung Poultry worker’s lung Turkey handling disease Canary fancier’s lung Duck fever
HP Associated with Veterinary Work and Animal Handling • • • Laboratory worker’s lung Pituitary snuff taker’s disease Furrier’s lung Bat lung Coptic lung (mummy handlers) Pearl oyster shell pneumonitis
HP Associated with Grain and Flour Processing • Grain measurer’s lung • Miller’s lung • Malt worker’s disease
HP Associated with Milling and Construction • • Wood dust pneumonitis Sequoisis Maple bark disease Wood trimmer’s disease Suberosis (moldy cork) Composter’s lung Thatched-roof lung
HP Associated with Plastics, Painting, Electronics, Etc. • • • Chemical HP – Toluene diisocyanate Detergent worker’s lung Pauli’s reagent alveolitis Vineyard sprayer’s lung Bible printer’s lung Epoxy resin lung
HP in Textile Workers • • Byssinosis (brown lung) – cotton “Velvet” worker’s lung Upholstery fabric workers Lycoperdonosis (lycoperdon puffballs)
HP Treatment • Antigen avoidance • Corticosteroids – 0. 5 -1 mg/kg daily • Alternatives…
HP Prevention/Avoidance • • Reduction of antigen burden Design of facilities-moisture control Preventative maintenance, esp. HVAC Protective devices-filters, respirators
HP Prognosis • Farmer’s lung – most recover; 50% have chronic lung dis, but minor, usually emphysematous changes • Bird fancier’s lung – prognosis usually worse. Duration of exposure, older age, greater exposure, all tend toward worsened severity